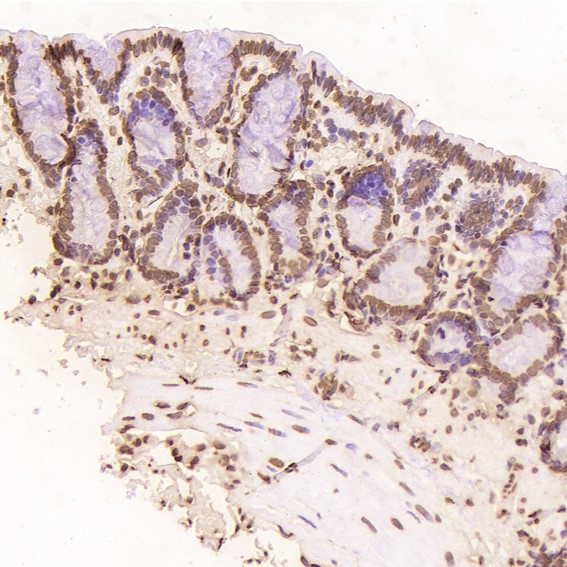

单克隆抗体
SOX2 Antibody (CY5268)
References (3)
UniProt:P48431
Application:WB,IHC,ICC/IF
Reactivity:Human,Mouse
Source:Rabbit mAb
SOX2 Antibody (CY5268)
UniProt:P48431
Application:WB,IHC,ICC/IF
Reactivity:Human,Mouse
Source:Rabbit mAb
References(3)
http://www.abways.cn/showproduct.asp?cid=CY5268
Histone H2A.X Antibody (CY5269)
References (1)
UniProt:P16104
Application:WB,IHC,ICC/IF,IP
Reactivity:Human,Mouse,Rat
Source:Rabbit mAb
Histone H2A.X Antibody (CY5269)
UniProt:P16104
Application:WB,IHC,ICC/IF,IP
Reactivity:Human,Mouse,Rat
Source:Rabbit mAb
References(1)
http://www.abways.cn/showproduct.asp?cid=CY5269
ErbB3 (HER3) Antibody (CY5270)
UniProt:P21860
Application:WB,IP
Reactivity:Human,Rat
Source:Rabbit mAb
ErbB3 (HER3) Antibody (CY5270)
UniProt:P21860
Application:WB,IP
Reactivity:Human,Rat
Source:Rabbit mAb
http://www.abways.cn/showproduct.asp?cid=CY5270
Phospho-PKR (T446) Antibody (CY5271)
UniProt:P19525
Application:WB,IHC,IP,ChIP
Reactivity:Human
Source:Rabbit mAb
Phospho-PKR (T446) Antibody (CY5271)
UniProt:P19525
Application:WB,IHC,IP,ChIP
Reactivity:Human
Source:Rabbit mAb
http://www.abways.cn/showproduct.asp?cid=CY5271
Histone H3 (acetyl K14) Antibody (CY5272)
UniProt:P68431
Application:WB,IHC,ICC/IF,IP
Reactivity:Human,Rat
Source:Rabbit mAb
Histone H3 (acetyl K14) Antibody (CY5272)
UniProt:P68431
Application:WB,IHC,ICC/IF,IP
Reactivity:Human,Rat
Source:Rabbit mAb
http://www.abways.cn/showproduct.asp?cid=CY5272

销售咨询
销售咨询 一键电话
一键电话